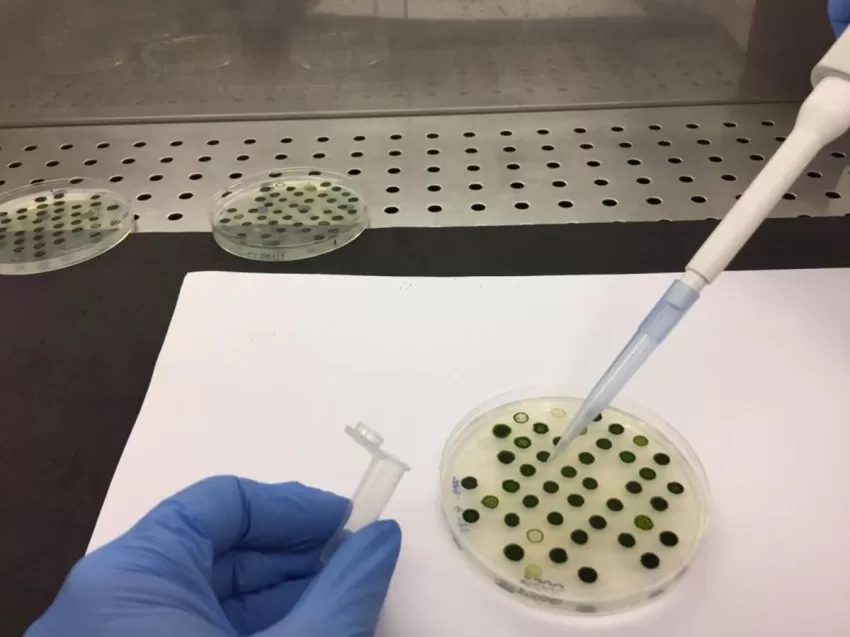

Diseñan un fármaco con biomoléculas de piel de rana para combatir enfermedades en especies acuícolas
Un equipo de investigación de las universidades de Huelva, Murcia y Sevilla ha diseñado un fármaco con biomoléculas del sistema inmune de los peces y de la piel de rana para combatir las enfermedades más habituales de la acuicultura.
Según ha informado la Fundación Descubre, este nuevo tratamiento se presenta como una alternativa más eficaz y económica a los antibióticos que se emplean normalmente y es eficaz ante una amplia diversidad de virus y bacterias de este sector. Además, posee propiedades antifúngicas, es decir, evita la presencia de hongos y, una vez encapsulado, la medicación podrá suministrase vía oral con el alimento de los peces en vez de diseminarse en el agua, lo que afectaría menos al entorno que habitan las especies acuícolas.
Los antibióticos habituales presentan limitaciones como la resistencia que desarrollan las bacterias a ellos y no son eficaces ante los virus. Las infecciones causan altas tasas de mortalidad, especialmente entre los ejemplares de peces más jóvenes, que son los más susceptibles a las infecciones al poseer un sistema inmune más inmaduro. "La alternativa que proponemos intenta paliar estos problemas y ya se está ensayando en especímenes jóvenes de especies como la lubina", explica a la Fundación Descubre la investigadora de la Universidad de Huelva Rosa León.
En el estudio 'Influence of adding terminal tags on the structural and antimicrobial properties of the peptide caerin 1.1' publicado en Aquaculture, los científicos explican que modificaron los péptidos Caerina 1.1 y NK-Lisina presentes en la piel de las ranas y en el propio sistema inmunitario de los peces respectivamente. Éstas moléculas contienen aminoácidos que se agrupan formando una cadena en forma de hélice.
"Tienen una función de vital importancia en el sistema inmune innato de muchos seres vivos, incluidos los humanos, puesto que reaccionan a los agentes patógenos y defienden el organismo de los mismos", comenta León.
MOLÉCULAS MODIFICADAS
En su propuesta, los científicos modificaron la cadena de los péptidos añadiendo nuevos eslabones al final de la misma. De este modo, lograron que las moléculas fueran más eficaces ante las enfermedades virales y bacterianas. Por ejemplo, la propuesta de este equipo de investigación es eficaz ante patógenos como la bacteria Photobacterium damselae, causante de la fotobacteriosis o el virus de la necrosis nerviosa viral, que afecta al sistema nervioso de los peces.
Para comprobar la eficacia de los péptidos como alternativa a los antibióticos, los investigadores realizaron el estudio 'in vitro'. Introdujeron estas moléculas modificadas dentro de placas en el laboratorio donde las enfrentaron a agentes patógenos habituales en la acuicultura y comprobaron que eran eficaces ante quince tipos de bacterias y cuatro virus.
Después, el Departamento de Biología Celular e Histología de la Universidad de Murcia realizó un estudio in vivo e inocularon los péptidos a ejemplares vivos de lubina y observaron cómo respondían a los distintos agentes patógenos. De este modo, confirmaron su eficacia.
Según la FAO, la acuicultura produce el 53% de los peces que se consumen en el mundo. Sin embargo, esta práctica se enfrenta a retos como la presencia de enfermedades en los tanques, así como la resistencia a los antibióticos que los patógenos desarrollan ante su uso masivo. Esto se produce porque las bacterias van adaptando su metabolismo hasta que los medicamentos dejan de hacerles efecto.
El siguiente reto al que se enfrentan los investigadores es el de estabilizar los péptidos, es decir, encontrar la forma de que tarden más en degradarse dentro del organismo una vez consumidos para prolongar la duración de sus efectos.
Además, los investigadores del grupo 'Unidad de mejora genética de organismos fotosintéticos del RENSMA' de la Universidad de Huelva están diseñando diferentes medios como nanopartículas o microalgas para encapsular estos fármacos. De este modo, podrán concentrarlos y suministrarlos por vía oral a los peces, sin necesidad de diseminar un fármaco en el entorno en el que habitan. "Se trata de un método más económico, más eficiente y que afecta menos al medio ambiente", añade esta experta.
Este trabajo ha sido financiado por fondos propios de la Universidad de Huelva, el Fondo Europeo de Desarrollo Regional (Feder) y el Ministerio de Ciencia e Innovación.
Queremos saber qué te ha parecido
Noticias Relacionadas
El Gobierno regional destaca el papel de la universidad y la ciencia como palancas para reforzar el tejido productivo de la Región
02 de Julio, 2026
El consejero Juan María Vázquez visita las instalaciones de Hefame, en Santomera, y subraya que la futura Ley de Universidades y la Ley de la Ciencia consolidarán un sistema más conectado con la s...El Gobierno regional pone la innovación digital al servicio del medio rural y marino con el proyecto 'TriRuralTech'
01 de Julio, 2026
La iniciativa es uno de los proyectos del programa Redes Territoriales de Especialización Tecnológica (Retech), impulsada por la Fundación Integra con colaboración del Imida El plan incorpora nuev...La Comunidad acerca la innovación de las empresas regionales a los ayuntamientos para mejorar los servicios públicos
27 de Junio, 2026
El programa Tracción Local, organizado por el Info, reúne a nueve municipios y cerca de una treintena de startups y empresas innovadoras con soluciones aplicables a la gestión municipal La jornada ...El Gobierno regional sitúa 'Todos Somos Campus' como ejemplo del modelo inclusivo para las futuras leyes de Universidades y Ciencia
24 de Junio, 2026
Juan María Vázquez destaca en la clausura del programa de la UMU que ambas normas incorporan la igualdad de oportunidades, la accesibilidad y la empleabilidad como ejes de la educación superior y d...



